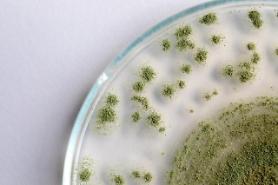
Các nhà nghiên cứu Hàn Quốc phát hiện loại nấm mốc có khả năng phân hủy các thành phần nhựa sinh học

[Gettyimages Bank]
Chính phủ Hàn Quốc đã hợp tác với một viện nghiên cứu nhà nước để phát triển hệ thống giao hàng bằng máy bay không người lái và robot tự động giao hàng tạp hóa cho khách hàng sống trên một hòn đảo nhỏ bên kia eo biển hẹp.
Máy bay không người lái giao hàng và robot tự động được các tổ chức chính phủ và công ty tư nhân nghiên cứu rộng rãi vì tính linh hoạt và tiện lợi của chúng. Drone đã được thử nghiệm để cung cấp thuốc cho những người sống trên các đảo nhỏ. Woowa Brothers, nhà điều hành ứng dụng dịch vụ giao đồ ăn yêu thích của Hàn Quốc Baedal Minjok, đã thử nghiệm robot tự động để giao đồ ăn trong năm nay.
Bộ Thương mại, Công nghiệp và Năng lượng Hàn Quốc đã hợp tác với cơ quan Điện tử và Viễn thông Viện nghiên cứu nhà nước (ETRI) để phát triển một dịch vụ bay không người lái kết hợp tại Yeosu 315 km (195 dặm) về phía nam Seoul.
Một khách hàng ở Jangdo, một hòn đảo nhỏ ngoài khơi Yeosu, đã đặt hàng tạp hóa bằng ứng dụng do GS25, một cửa hàng tiện lợi lớn trong nước cung cấp. Khi mệnh lệnh được đưa ra, một máy bay không người lái chở hàng tạp hóa đã cất cánh từ một trạm xăng do GS Caltex, một công ty lọc dầu lớn ở Hàn Quốc điều hành, để bay qua một eo biển hẹp. Trong chuyến bay của mình, máy bay không người lái đạt độ cao tối đa khoảng 80 mét (262 feet).
Khi máy bay không người lái đến một khu vực cỏ trống ở Jangdo, nó hạ xuống khoảng một mét so với một rô bốt tự động và nhẹ nhàng thả tải xuống khoang chứa của rô bốt giống máy kéo trước khi bay trở lại trạm gốc của nó ở Yeosu. Robot tự hành di chuyển khoảng 700 mét để đến đích. Hoạt động diễn ra trong khoảng 10 phút.
Máy bay không người lái giao hàng có khả năng mang tối đa 5 kg (11 pound) và bay với tốc độ tối đa 60 km một giờ. Nó có thể ở trong không khí lên đến 30 phút. Robot tự hành có thể mang tải trọng tối đa 150 kg mỗi lần và điều hướng trong tối đa 300 phút với tốc độ 5,0 km mỗi giờ.
Chuyến bay thử nghiệm là một phần của dự án nhà nước trị giá 35,2 tỷ won (30 triệu USD) nhằm nuôi dưỡng cơ sở hạ tầng phân phối và hậu cần không trực diện sử dụng 5G, máy bay không người lái, robot và trí tuệ nhân tạo.
Vào tháng 6, GS Caltex đã sử dụng máy bay không người lái giao hàng để mang hộp cơm trưa và đồ uống từ một trạm xăng ở đảo nghỉ mát phía nam Jeju đến một trường tiểu học gần đó. GS Caltex có kế hoạch sử dụng mạng lưới các trạm xăng trên toàn quốc của mình làm trung tâm của hệ thống hậu cần có thể cung cấp dịch vụ giao hàng bằng máy bay không người lái, chia sẻ xe hơi, chuyển bưu kiện bằng xe và tính phí cho những chiếc xe thân thiện với môi trường.
Hàn Quốc với mạng lưới liên lạc di động 4G và 5G đã thử nghiệm máy bay không người lái giao hàng ở các khu vực đô thị và những nơi khó tiếp cận. Nhu cầu giao bưu kiện bằng máy bay không người lái nhanh chóng ở những người dân sống trên các hòn đảo trải dài bờ biển phía Tây Nam và phía Nam do các công ty hậu cần tính phí giao hàng đến các đảo cao hơn.
Để thương mại hóa máy bay không người lái giao hàng ở các khu vực đô thị, một công ty dịch vụ giao đồ ăn đã trình diễn một máy bay không người lái lái tự động ở thành phố cảng phía tây Incheon vào năm 2016 để giao món bánh gạo cho khách hàng.
© Bản quyền thuộc về Thời báo Kinh tế AJU & www.ajunews.com: Việc sử dụng các nội dung đăng tải trên vietnam. kyungjeilbo.com phải có sự đồng ý bằng văn bản của Aju News Corporation.